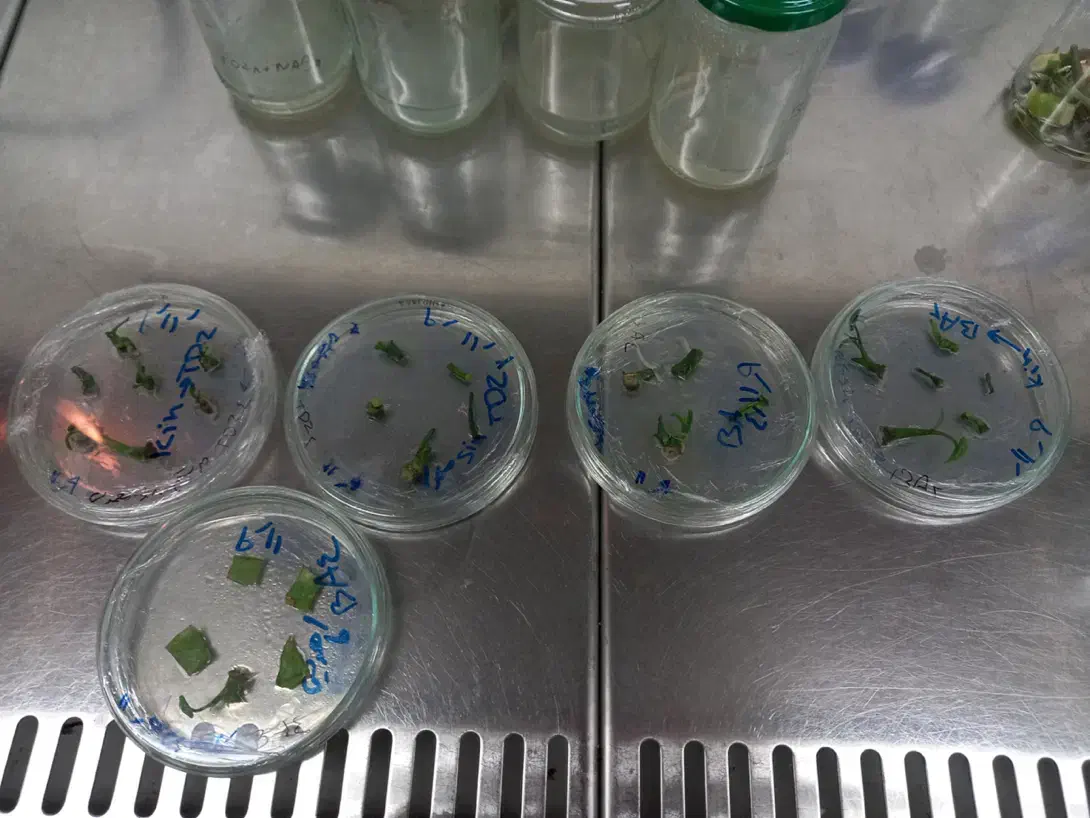
درخواست همکاری در زمینه کشت بافت گیاهی (اراک)|خدمات باغبانی و درختکاری|اراک, |دیوار

درخواست همکاری در زمینه کشت بافت گیاهی (اراک)
توضیحات
سلام وقت بخیر فارغالتحصیل کارشناسی ارشد رشته گیاهان زینتی و فضای سبز هستم و در زمینههای کشت بافت گیاهی، ریزازدیادی و تولید گیاهان زینتی تخصص و تجربه دارم. به همکاری در محیطهای آزمایشگاهی یا تولیدی مرتبط با کشت بافت گیاهان در شهر اراک یا استان مرکزی علاقهمندم و آماده کار بهصورت تماموقت یا پارهوقت با حقوق هستم. با تسلط بر کار در محیط استریل، آشنایی با مراحل آمادهسازی محیط کشت، انتقال ریزنمونه و نگهداری کلونها، میتوانم در پروژههای تکثیر و تولید انبوه گیاهان مشارکت موثری داشته باشم. در صورت تمایل به همکاری، لطفا پیام بدین
یادداشت تنها برای شما قابل دیدن است و پس از حذف آگهی، پاک خواهد شد.